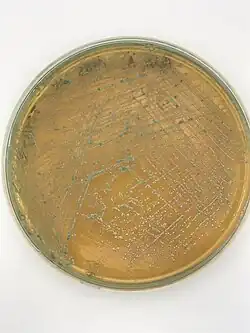

Pediococcus acidilactici
| Pediococcus acidilactici | |
|---|---|
| |
| Pediococcus acidilactici colonies on an MRS agar plate | |
| Scientific classification | |
| Domain: | |
| Phylum: | |
| Class: | |
| Order: | |
| Family: | |
| Genus: | |
| Species: | P. acidilactici
|
| Binomial name | |
| Pediococcus acidilactici Lindner 1887
| |
Pediococcus acidilactici is a species of Gram-positive cocci that is often found in pairs or tetrads. P. acidilactici is a homofermentative bacterium that can grow in a wide range of pH, temperature, and osmotic pressure, therefore being able to colonize the digestive tract.[1] It has emerged as a potential probiotic that has shown promising results in animal and human experiments. However, some of the results are limited. They are commonly found in fermented vegetables, fermented dairy products, and meat.[2]
Pediococcus acidilactici is a facultative anaerobe that grows well on de Man, Rogosa, Sharpe agar of an optimum pH of 6.2, with an overnight incubation at 37 and 45 °C (99 and 113 °F). It is also viable at higher temperatures up to 65 °C (149 °F).[3]
This species is also acidophilic, and viable at very low pH. The probiotic P. acidilactici is a facultative anaerobe with lesser sensitivity to oxygen. Pediococci exert antagonism against other microorganisms, including enteric pathogens, primarily through the production of lactic acid and secretion of bacteriocins known as pediocins.[4][5]
Potential benefits
P. acidilactici has a wide range of potential benefits which are still being studied. Though it is being used as a probiotic supplement to treat constipation, and diarrhea, relieve stress, and enhance immune response among birds and small animals, human trials are still limited. P. acidilactici is also known to prevent colonization of the small intestine by pathogens such as Shigella spp., Salmonella spp., Clostridioides difficile, and Escherichia coli among small animals.
Digestive disorders
P. acidilactici has been used to treat dogs with digestive disorders and those infected by parvovirus. Before treatment with orally administered mixtures of P. acidilactici and Saccharomyces boulardii, the dogs diagnosed with parvovirus infection were shown to exhibit severe gastrointestinal distress such as vomiting and bloody diarrhea. After the treatment for three days, the bloody diarrhea ceased and the dogs had solid stools.[3]
Alternative medicine
P. acidilactici has not been stated in any literature to have toxic effects. Another potential benefit of using them as probiotics is their use as alternative medicines against infectious parasitic pathogens such as Eimeria in broiler chickens.[6] P. acidilactici in conjunction with S. boulardii stimulates humoral immune response to produce higher Eimeria-specific antibody levels while also reducing the number of oocysts shed by possible competitive inhibition and pediocin production, which inhibit pathogenic bacteria and other Gram-positive spoilage.[7][8]
Immune health benefits
P. acidilactici can function as an immune modulator.[9] Animals fed with P. acidilactici have shown enhanced immune responses against infectious coccidioidal diseases.[10][11]
Antibiotic treatment
Dogs typically undergo antibiotic treatment to eliminate infectious pathogens or parasites and to prevent secondary infections. However, the treatment with antibiotics can also disrupt the ecosystems of beneficial microorganisms in the dog's gastrointestinal (GI) tract. When dogs with digestive disorders were treated by antibiotics together with P. acidilactici probiotic products, the surviving millions of bacteria were able to alleviate the disrupted balance of microorganisms in dogs’ GI tracts caused by antibiotics treatment and to normalize the intestinal microflora.[12]
Moreover, since antibiotics kill many of competitive pathogenic microorganisms, Pediococcus products can have better beneficial effects in dogs and cats' GI tracts when administered with antibiotics.
Difference from other probiotic strains
Most strains of Lactobacillus and Bifidobacterium are sensitive to room temperature, which raises concerns for storage conditions and maintenance of cell viability. In addition, most Lactobacillus and Bifidobacterium species are sensitive to acidic exposure and have difficulty surviving environments with low pH, such as stomach acid.[12][11] Therefore, obtaining consistent and reproducible results becomes the major challenge for the commercial products of Lactobacillus and Bifidobacterium.
References
- ^ Klaenhammer T.R. 1993. Genetics of bacteriocins produced by lactic acid bacteria. FEMS Microbiol. Rev. 12 :39S-85S
- ^ Barros R.R., Carvalho G.S., Peralta J.M., Facklam R.R., Teixeira L.M. 2001. Phenotypic and genotypic characterization of Pediococcus strains isolated from human clinical sources. J. Clin Microbiol. April;39(4): 1241–1246.
- ^ a b Lin J.J. 2006. Probiotics as alternative Biomedicines for pets with digestive disorders
- ^ Daeschel M.A., Klaenhaemmer T.R. 1985. Association of a 13.6-megadalton plasmid in Pediococcus pentosaceus with bacteriocin activity. Appl. Environ. Microbiol. 50: 1538S-1541S
- ^ Zhu, Liyan; Zeng, Jianwei; Wang, Chang; Wang, Jiawei (2022-02-08). "Structural Basis of Pore Formation in the Mannose Phosphotransferase System by Pediocin PA-1". Applied and Environmental Microbiology. 88 (3): e0199221. doi:10.1128/AEM.01992-21. ISSN 1098-5336. PMC 8824269. PMID 34851716.
- ^ Dalloul R.A., Lillehoj H.S, Lee J.S., Lee S.H., Chung K.S. 2006. Immunopotentiating effect of a Fomitella fraxinea – derived lectin on chicken immunity and resistance to coccidiosis. Poult. Sci. 85: 446S-451S
- ^ Ennahar S., Deschamps N. 2000. Anti-Listeria effect of enoterocin A, produced by cheese-isolated Enterococcus faecium EFM01, relative to other bacteriocins from lactic acid bacteria. J.Appl. Microbiol. 88:449S-457S
- ^ Lee SH, Lillehoj HS, Dalloul RA, Park DW, Hong YH, and Lin JJ. 2007. Influence of Pediococcus –based probiotic on coccidiosis in broiler chickens. Poultry Sci. 86:63-66
- ^ Jha, Rajesh; Das, Razib; Oak, Sophia; Mishra, Pravin (2020). "Probiotics (Direct-Fed Microbials) in Poultry Nutrition and Their Effects on Nutrient Utilization, Growth and Laying Performance, and Gut Health: A Systematic Review". Animals. 10 (10): 1863. doi:10.3390/ani10101863. PMC 7602066. PMID 33066185.
- ^ Lee SH, Lillehoj HS, Park DW, Hong YH, and Lin JJ. 2007. Effects of Pediococcus –and Saccharomyces -based probiotic (MitoMax) on coccidiosis in broiler chickens. Comparative Immuno Microbiol & Infectious disease. 30:261-268
- ^ a b Lin J.J. 2006. Probiotics as alternative Biomedicines for pets with digestive disorders. Proceeding of 8th Annual meeting of JBVP. 3-288-292.
- ^ a b Mizutani W., Yamasaki R, Lin, JJ, Kuki M, and Kato G. 2007. Pediococcus-an [sic] unique probiotics we use as a novel GI supplement. Annual Meeting of JBVP. 3-269-3-272